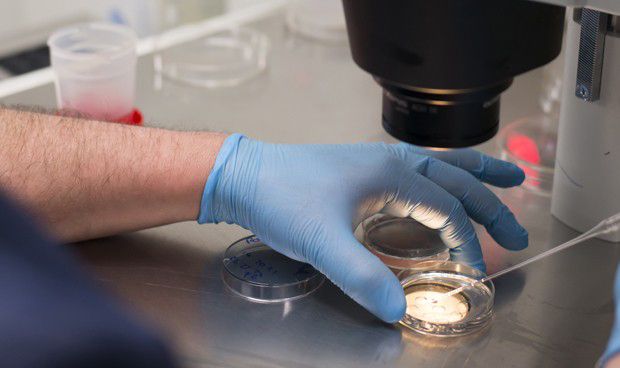
Un estudio muestra que la fertilidad masculina ha caído un 50% en Occidente

El estudio concluyente muestra que esta disminución espermática es fuerte y continuada.
El estudio internacional que ha publicado la revista Human Reproduction Update -en la que colabora la Universidad de Murcia (UMU)- ha publicado un análisis de los últimos cuarenta años que muestra que la concentración espermática se ha reducido más de un 50 por ciento en hombres occidentales.
Según fuentes de la Unidad de Cultura Científica y de la Innovación (UCC+I) de la UMU, esta investigación se ha realizado con estudios entre 1973 y 2011. Además, estos resultados muestran un importante descenso de la salud reproductiva masculina debido a su baja calidad seminal, con un mayor riesgo de hospitalación y muerte.
El proyecto -encabezado por la Escuela de Salud Pública y Medicina Comunitaria Hadassah Braun de la Universidad Hebrea y la Escuela de Medicina Icahn de Mount Sinai-, muestra que se ha producido una disminución significativa del 52,4 por ciento en la concentración espermática, así como un descenso del 59,3 por ciento en el recuento total, donde se incluyen hombres de América del Norte, Europa, Australia y Nueva Zelanda que no fueron seleccionados por su estatus de fertilidad.
Sin embargo, no se observó esta reducción en América del Sur, Asia y África, donde la cantidad de estudios ha sido menor. Todo ello se ha realizado mediante un cribaje de 7.500 estudios y la realización de un análisis de meta-regresión en 185 estudios.
Asimismo, también indica que la tasa de disminución no está decreciendo entre los hombres occidentales: la pendiente es muy inclinada y significativa, aun cuando los análisis se restringen a estudios que recolectaron muestras entre 1996 y 2011.
Este estudio concluyente muestra, por primera vez, que esta disminución es fuerte y continuada. El hecho de que este descenso se evidencie en los países occidentales sugiere que los químicos comercializados tienen un papel causal en esta tendencia.
 REGÍSTRATE GRATIS
REGÍSTRATE GRATIS
PARA SEGUIR LEYENDO
 ¿Ya eres premium? Inicia sesión
¿Ya eres premium? Inicia sesión

Aviso importante
El usuario desde el que está intentando acceder a este contenido no está registrado como profesional autorizado para acceder a esta información. Esta noticia informa sobre novedades farmacológicas y, por ley, está reservada a profesionales de la salud habilitados para la prescripción o dispensación de medicamentos.
Volver a la portada de Redacción Médica
Las informaciones publicadas en Redacción Médica contienen afirmaciones, datos y declaraciones procedentes de instituciones oficiales y profesionales sanitarios. No obstante, ante cualquier duda relacionada con su salud, consulte con su especialista sanitario correspondiente.